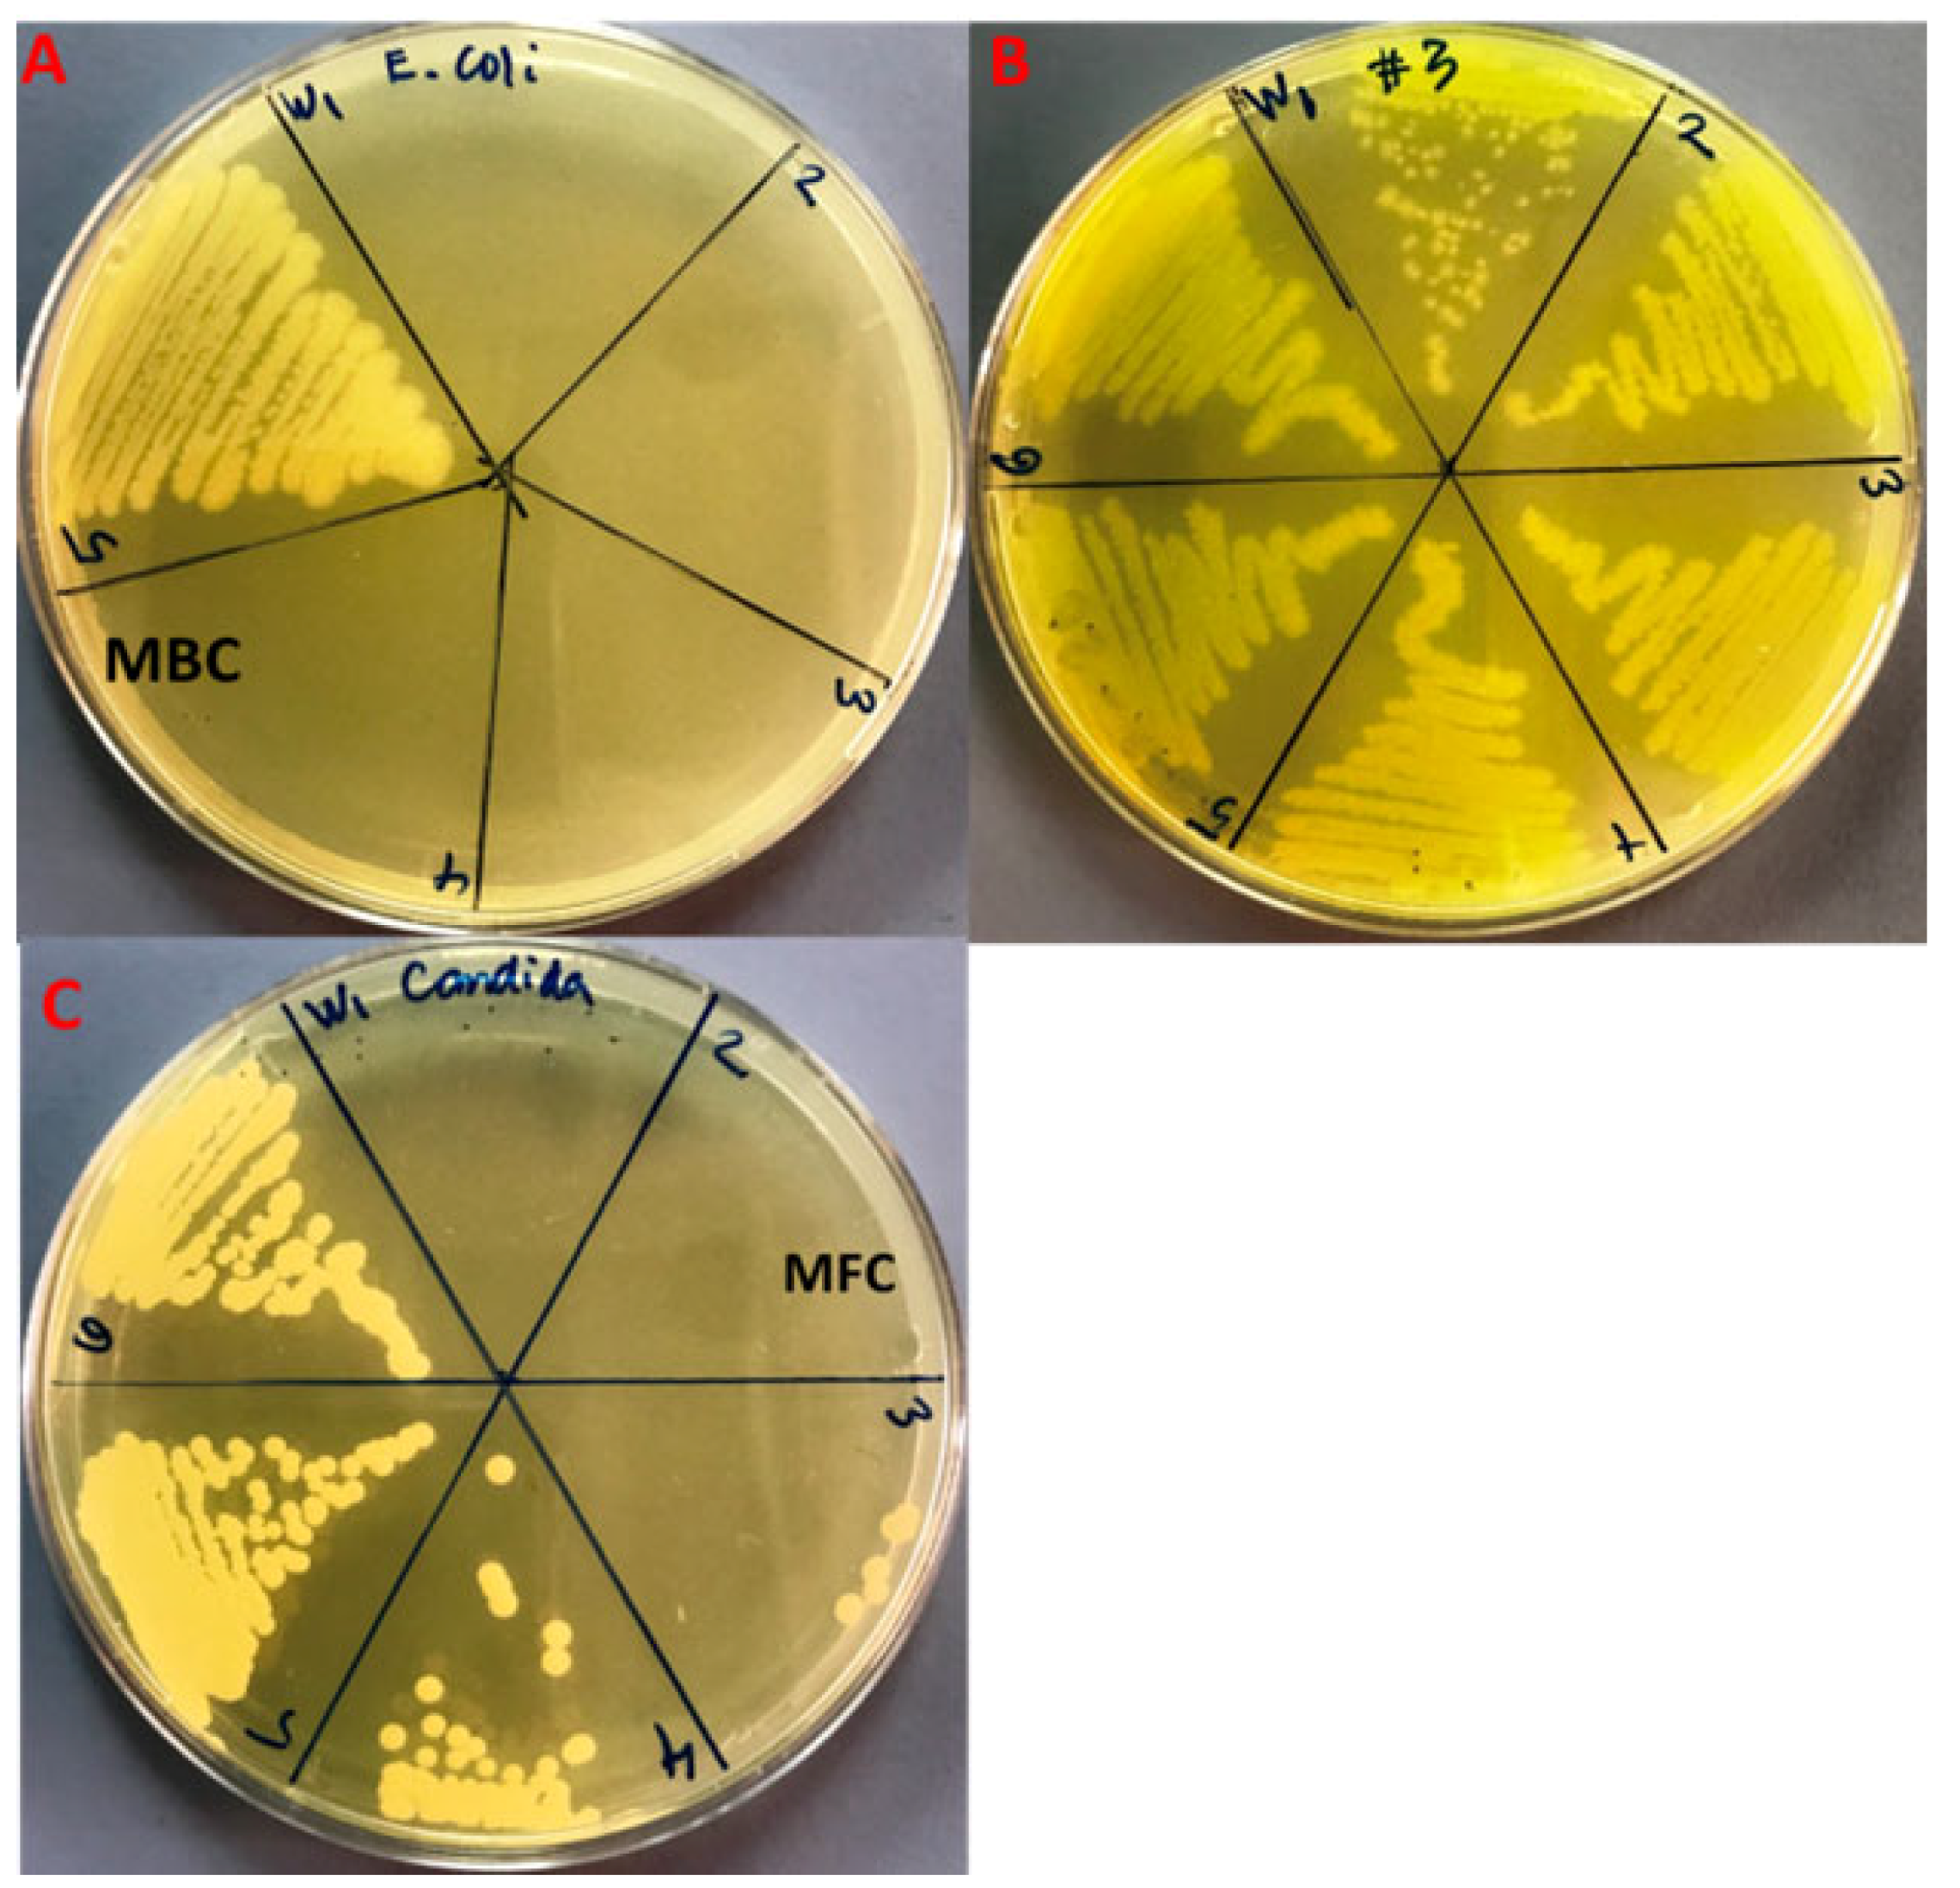
Plants 11 02395 g007 550

Antibacterial, Anticandidal, and Antibiofilm Potential of Fenchone: In Vitro, Molecular Docking and In Silico/ADMET Study
Abstract
:1. Introduction
2. Results and Discussion
2.1. Pharmacokinetic/ADME Properties of Fenchone
2.2. Physicochemical Properties of 1, 3-β–D-Glucan Synthase and Anthranilate-CoA Ligase
2.3. Modeling of 3D Structure of Protein
2.4. Structure Validation
2.5. Molecular Docking
2.6. Antimicrobial Activity of Fenchone
2.7. Inhibition of Biofilm Formation
3. Materials and Methods
3.1. Retrieval of the Ligand Molecule and Protein Structure for ADME Studies
3.2. Molecular Docking Analysis
3.3. Evaluation of Antibacterial and Antifungal Activity
3.4. Minimal Inhibitory Concentration (MIC)
3.5. Minimal Bacterial and Fungicidal Concentration (MBC and MFC)
3.6. Evaluation of Anti-Biofilm Activity
3.7. Statistical Analysis
4. Conclusions
Author Contributions
Funding
Institutional Review Board Statement
Informed Consent Statement
Data Availability Statement
Acknowledgments
Conflicts of Interest
References
- Aslam, B.; Wang, W.; Arshad, M.I.; Khurshid, M.; Muzammil, S.; Rasool, M.H.; Nisar, M.A.; Alvi, R.F.; Aslam, M.A.; Qamar, M.U.; et al. Antibiotic resistance: A rundown of a global crisis. Infect. Drug Resist. 2018, 11, 1645. [Google Scholar] [CrossRef] [PubMed]
- Badgujar, S.B.; Pate, V.V.; Bandivdekar, A.H. Foeniculum vulgare Mill: A Review of Its Botany, Phytochemistry, Pharmacology, Contemporary Application, and Toxicology. BioMed. Res. Int. 2014, 2014, 842674. [Google Scholar] [CrossRef] [PubMed]
- Choi, E.M.; Hwang, J.K. Anti-Inflammatory, Analgesic and Antioxidant Activities of The Fruit of Foeniculum vulgare. Fitoterapia 2004, 75, 557–565. [Google Scholar] [CrossRef]
- Keskin, I.; Gunal, Y.; Ayla, S.; Kolbasi, B.; Sakul, A.; Kilic, U.; Gok, O.; Koroglu, K.; Ozbek, H. Effects of Foeniculum vulgare essential oil compounds, fenchone and limonene, on experimental wound healing. Biotech. Histochem. 2017, 92, 274–282. [Google Scholar] [CrossRef] [PubMed]
- Ozbek, H. Investigation of lethal dose levels and anti-inflammatory effect of Fenchone. Turk. Hij ve Deney Biyol Dergisi. 2007, 64, 22–25. [Google Scholar]
- Rohman, F.; Putra, W.E. The bioinformatics perspective of Foeniculum vulgare fruit’s bioactive compounds as natural anti-hyperglycemic against alpha-glucosidase. Biodivers. J. 2021, 22, 79–84. [Google Scholar]
- Singh, S.; Gupta, P.; Gupta, J. Virtual Structural Similarity Elucidates Bioactivity of Fenchone: A Phytochemical Enriched in Fennel Essential Oil. Curr. Drug Discov. Technol. 2020, 17, 619–630. [Google Scholar] [CrossRef]
- Him, A.; Ozbek, H.; Turel, I.; Oner, A.C. Antinociceptive activity of alpha-pinene and fenchone. Pharmacologyonline 2008, 3, 363–369. [Google Scholar]
- Pappas, P.G.; Kauffman, C.A.; Andes, D.R.; Clancy, C.J.; Marr, K.A.; Ostrosky-Zeichner, L.; Reboli, A.C.; Schuster, M.G.; Vazquez, J.A.; Walsh, T.J.; et al. Clinical practice guideline for the management of candidiasis: 2016 update by the infectious diseases society of America. Clin. Infect. Dis. 2016, 62, e1–e50. [Google Scholar] [CrossRef]
- Wächtler, B.; Citiulo, F.; Jablonowski, N.; Förster, S.; Dalle, F.; Schaller, M.; Wilson, D.; Hube, B. Candida albicans-epithelial interactions: Dissecting the roles of active penetration, induced endocytosis and host factors on the infection process. PLoS ONE 2012, 7, e36952. [Google Scholar] [CrossRef]
- Pfuller, R.; Graser, Y.; Erhard, M.; Groenewald, M. A novel flucytosineresistant yeast species, Candida pseudoaaseri, causes disease in a cancer patient. J. Clin. Microbiol. 2011, 49, 4195–4202. [Google Scholar] [CrossRef] [PubMed]
- Brown, G.D.; Gordon, S. Immune recognition of fungal beta-glucans. Cell Microbiol. 2005, 7, 471–479. [Google Scholar] [CrossRef] [PubMed]
- Houšť, J.; Spížek, J.; Havlíček, V. Antifungal Drugs. Metabolites 2020, 10, 106. [Google Scholar] [CrossRef] [PubMed] [Green Version]
- Andriole, V.T.; Bodey, G.P. Pocket Guide to Systemic Antifungal Therapy; Springfield, N.J., Ed.; Scientific Therapeutics Information: Madison, NJ, USA, 1994. [Google Scholar]
- Denning, D.W. Echinocandin antifungal drugs. Lancet 2003, 362, 1142–1151. [Google Scholar] [CrossRef]
- Hector, R.F. Compounds active against cell walls of medically important fungi. Clin. Microbiol Rev. 1993, 6, 1–21. [Google Scholar] [CrossRef]
- Bowman, S.M.; Free, S.J. The structure and synthesis of the fungal cell wall. BioEssays 2006, 28, 799–808. [Google Scholar] [CrossRef]
- Page, M.G.; Heim, J. Prospects for the next anti-Pseudomonas drug. Curr. Opin. Pharmacol. 2009, 9, 558–565. [Google Scholar] [CrossRef]
- Zavascki, A.P.; Carvalhaes, C.G.; Picao, R.C.; Gales, A.C. Multidrugresistant Pseudomonas aeruginosa and Acinetobacter baumannii: Resistance mechanisms and implications for therapy. Exp. Rev. Anti Infect. Ther. 2010, 8, 71–93. [Google Scholar] [CrossRef]
- Strateva, T.; Yordanov, D. Pseudomonas aeruginosa—A phenomenon of bacteria resistance. J. Med. Microbiol. 2009, 58, 1133–1148. [Google Scholar] [CrossRef]
- Moradali, M.F.; Ghods, S.; Rehm, B.H. Pseudomonas aeruginosa lifestyle: A paradigm for adaptation, survival, and persistence. Front. Cell. Infect. Microbiol. 2017, 15, 39. [Google Scholar]
- De Kievit, T.R. Quorum sensing in Pseudomonas aeruginosa biofilms. Environ. Microbiol. 2009, 11, 279–288. [Google Scholar] [CrossRef] [PubMed]
- Thi, M.T.; Wibowo, D.; Rehm, B.H. Pseudomonas aeruginosa biofilms. Int. J. Mol. Sci. 2020, 21, 8671. [Google Scholar] [CrossRef] [PubMed]
- Castillo-Juárez, I.; Maeda, T.; Mandujano-Tinoco, E.A.; Tomás, M.; Pérez-Eretza, B.; García-Contreras, S.J.; Wood, T.K.; García-Contreras, R. Role of quorum sensing in bacterial infections. World J. Clin. Cases 2015, 3, 575–598. [Google Scholar] [CrossRef]
- Waters, C.M.; Bassler, B.L. Quorum sensing: Cell-to-cell communication in bacteria. Annu. Rev. Cell Dev. Biol. 2005, 21, 319–346. [Google Scholar] [CrossRef] [PubMed] [Green Version]
- Xiao, G.; Déziel, E.; He, J.; Lépine, F.; Lesic, B.; Castonguay, M.H.; Milot, S.; Tampakaki, A.P.; Stachel, S.E.; Rahme, L.G. MvfR, a key Pseudomonas aeruginosa pathogenicity LTTR-class regulatory protein, has dual ligands. Mol. Microbiol. 2006, 62, 1689–1699. [Google Scholar] [CrossRef]
- Grandclément, C.; Tannières, M.; Moréra, S.; Dessaux, Y.; Faure, D. Quorum quenching: Role in nature and applied developments. FEMS Microbiol Rev. 2016, 40, 86–116. [Google Scholar] [CrossRef]
- Shaker, B.; Ahmad, S.; Thai, T.D.; Eyun, S.I.; Na, D. Rational Drug Design for Pseudomonas aeruginosa PqsA Enzyme: An in silico Guided Study to Block Biofilm Formation. Front. Mol. Biosci. 2020, 7, 577316. [Google Scholar] [CrossRef]
- Singleton, P. Bacteria in biology. In Biotechnology and Medicine, 5th ed.; Wiley: Hoboken, NJ, USA, 1999; pp. 444–454. [Google Scholar]
- Vogt, R.L.; Dippold, L. Escherichia coli O157:H7 outbreak associated with consumption of ground beef. Public Health Rep. 2005, 120, 174–178. [Google Scholar] [CrossRef]
- Sabbagh, G.; Berakdar, N. Docking studies of flavonoid compounds as inhibitors of β-ketoacyl acyl carrier protein synthase I (Kas I) of Escherichia coli. J. Mol. Graph. Model. 2015, 61, 214–223. [Google Scholar] [CrossRef]
- Price, A.C.; Choi, K.H.; Heath, R.J.; Li, Z.; White, S.W.; Rock, C.O. Inhibition of β-ketoacyl-acyl carrier protein synthases by thiolactomycin and cerulenin: Structure and mechanism. J. Biol. Chem. 2001, 276, 6551–6559. [Google Scholar] [CrossRef]
- Richard, J.H.; Suzane, J.; Charles, O.R. Fatty Acid and Phospholipid Metabolismin Prokaryotes. In Biochemisty of Lipids, Lipoproteins and Membranes, 4th ed.; Elsevier Science: Amsterdam, The Netherlands, 2002; Volume 36, pp. 55–92. [Google Scholar]
- Zhang, H.; Machutta, C.A.; Tonge, P.J. Fatty Acid Biosynthesis and Oxidation; Stony Brook University: Stony Brook, NY, USA, 2010. [Google Scholar]
- Sivakumar, K.; Balaji, S.; Gangaradhakrishna, N. In silico characterization of antifreeze proteins using computational tools and servers. J. Chem. Sci. 2007, 119, 571–579. [Google Scholar] [CrossRef]
- Gasteiger, E.; Hoogland, C.; Gattiker, A.; Duvaud, S.; Wilkins, M.R.; Appel, R.D.; Bairoch, A. Protein Identification and Analysis Tools on the ExPASy Server. In The Proteomics Protocols Handbook; John, M.W., Ed.; Humana Press: Totowa, NY, USA, 2005; pp. 571–607. [Google Scholar]
- Chhetri, A.; Loksztejn, A.; Yokoyama, K. Quantitative Characterization of the Amount and Length of (1,3)-β-d-glucan for Functional and Mechanistic Analysis of Fungal (1,3)-β-d-glucan Synthase. Bio Protoc. 2021, 11, e3995. [Google Scholar] [CrossRef] [PubMed]
- Sivakumar, K. Biocomputation and Biomedical Informatics: Case Studies and Applications, 1st ed.; Lazakidou, A., Ed.; Medical Information Science Reference (an imprint of IGI Global); University of Peloponnese: Tripoli, Greece, 2010; pp. 143–157. [Google Scholar]
- Zhou, H.; Skolnick, J. Ab initio protein structure prediction using chunk-TASSER. Biophys. J. 2007, 93, 1510–1518. [Google Scholar] [CrossRef] [PubMed]
- Yang, J.; Zhang, Y. Protein Structure and Function Prediction Using I-TASSER. Curr. Protoc. Bioinform. 2015, 52, 5.8.1–5.8.15. [Google Scholar] [CrossRef]
- Wiederstein, M.; Sippl, M.J. ProSA-web: Interactive web service for the recognition of errors in three-dimensional structures of proteins. Nucleic Acids Res. 2007, 35, W407–W410. [Google Scholar] [CrossRef]
- Yadav, M.; Alka, S.; Sushma, R.; Eva, L. Structural modeling and simulation studies of Brugia malayi glutathione-S-transferase with compounds exhibiting antifilarial activity: Implications in drug targeting and designing. J. Mol. Graph. Model. 2010, 28, 435–445. [Google Scholar] [CrossRef]
- Hasan, M.A.; Mazumder, H.H.; Chowdhury, A.S.; Datta, A.; Khan, M.A. Molecular-docking study of malaria drug target enzyme transketolase in Plasmodium falciparum 3D7 portends the novel approach to its treatment. Biol. Med. 2015, 10, 7. [Google Scholar] [CrossRef]
- Douglas, C.M.; Foor, F.; Marrinan, J.A.; Morin, N.; Nielsen, J.B.; Dahl, A.M.; Baginsky, W.; Li, W.; EL-Sherbeini, M.; Clemas, J.A.; et al. The Saccharomyces cerevisiae FKSI (ETGJ) gene encodes an integral membrane protein which is a subunit of 1,3-,8-Dglucan synthase. Proc. Natl. Acad. Sci. USA 1994, 91, 12907–12911. [Google Scholar] [CrossRef]
- Beauvais, A.; Bruneau, J.M.; Mol, P.C.; Buitrago, M.J.; Legrand, R.; Latge, J.P. Glucan synthase complex of Aspergillus fumigatus. J. Bacteriol. 2001, 183, 2273–2279. [Google Scholar] [CrossRef]
- Gulfraz, M.; Mehmood, S.; Minhas, N.; Jabeen, N.; Kausar, R.; Jabeen, K.; Arshad, G. Composition and antimicrobial properties of essential oil of Foeniculum vulgare. Afr. J. Biotechnol. 2008, 17, 4364–4368. [Google Scholar]
- Bassyouni, R.H.; Wali, I.E.; Kamel, Z.; Kassim, M.F. Fennel oil: A promising antifungal agent against biofilm forming fluconazole resistant Candida albicans causing vulvovaginal candidiasis. J. Herb. Med. 2019, 15, 100227. [Google Scholar] [CrossRef]
- Kawther, F.A. Antimicrobial Activity of Essential Oils of some Medicinal Plants from Saudi Arabia. Saudi J. Biol Sci. 2007, 14, 53–60. [Google Scholar]
- Roby, M.H.; Sarhan, M.A.; Selim, K.A.; Khalel, K.I. Antioxidant and antimicrobial activities of essential oil and extracts of fennel (Foeniculum vulgare L.) and chamomile (Matricaria chamomilla L.). Ind. Crops Prod. 2013, 44, 437–445. [Google Scholar] [CrossRef]
- Medina, E.; Castro, D.; Romero, A.C.; Brenes, M. Comparison of the Concentrations of Phenolic Compounds in Olive Oils and Other Plant Oils: Correlation with Antimicrobial Activity. J. Agric. Food Chem. 2006, 54, 4954–4961. [Google Scholar] [CrossRef]
- Lamber, R.J.; Skandamis, P.N.; Coote, P.J.; Nycas, G.J. A Study of the Minimum Inhibitory Concentration and Mode of Action of Oregano Essential Oil, Thymol and Carvacrol. J. Appl Microbiol. 2001, 91, 453–462. [Google Scholar] [CrossRef]
- Popović, V.B.; Petrović, S.D.; Milenković, M.T.; Drobac, M.M.; Couladis, M.A.; Niketić, M.S. Composition and Antimicrobial Activity of the Essential Oils of Laserpitium latifolium L. and L. ochridanum Micevski (Apiaceae). Chem. Biodivers. 2015, 12, 170–177. [Google Scholar] [CrossRef]
- Walsh, S.E.; Maillard, J.Y.; Russell, A.D.; Catrenich, C.E.; Charbonneau, D.L.; Bartolo, R.G. Activity and Mechanism of Action of Selected Biocidal Agents on Gram-Positive and -Negative Bacteria. J. Appl. Microbiol. 2003, 94, 240–247. [Google Scholar] [CrossRef]
- Upadhyay, R.K.; Dwivedi, P.; Ahmad, S. Antifungal Activity of 16 Plant Essential Oils against S. cerevisiae, Rhizopus stolonifer and Aspergillus flavus. J. Pharm. Res. 2011, 4, 1153–1156. [Google Scholar]
- Upadhyay, R.K.; Dwivedi, P.; Ahmad, S. Screening of Antibacterial Activity of Six Plant Essential Oils against Pathogenic Bacterial Strains. Asian J. Med. Sci. 2010, 2, 152–158. [Google Scholar]
- Kwiatkowski, P.; Grygorcewicz, B.; Pruss, A.; Wojciuk, B.; Giedrys-Kalemba, S.; Dołêgowska, B.; Zielińska-Bliźniewska, H.; Olszewski, J.; Sienkiewicz, M.; Kochan, E. Synergistic effect of fennel essential oil and hydrogen peroxide on bacterial biofilm. Postȩpy Dermatol. Alergol. 2020, 37, 690. [Google Scholar] [CrossRef]
- Kim, Y.G.; Lee, J.H.; Gwon, G.; Kim, S.I.; Park, J.G.; Lee, J. Essential oils and eugenols inhibit biofilm formation and the virulence of Escherichia coli O157: H7. Sci. Rep. 2016, 6, 1. [Google Scholar] [CrossRef] [PubMed]
- Daina, A.; Zoete, V. Swiss ADME: A free web tool to evaluate pharmacokinetics, druglikeness and medicinal chemistry friendliness of small molecules. Sci. Rep. 2017, 7, 42717. [Google Scholar] [CrossRef] [PubMed]
- Berman, H.M. The Protein Databank: A historical perspective. Acta Cryst. 2008, 64, 88–95. [Google Scholar] [CrossRef] [PubMed]
- Ansari, M.A.; Kalam, A.; Al-Sehemi, A.G.; Alomary, M.N.; AlYahya, S.; Aziz, M.K.; Srivastava, S.; Alghamdi, S.; Akhtar, S.; Almalki, H.D.; et al. Counteraction of Biofilm Formation and Antimicrobial Potential of Terminalia catappa Functionalized Silver Nanoparticles against Candida albicans and Multidrug-Resistant Gram-Negative and Gram-Positive Bacteria. Antibiotics 2021, 10, 725. [Google Scholar] [CrossRef]
- Ansari, M.A.; Akhtar, S.; Rauf, M.A.; Alomary, M.N.; AlYahya, S.; Alghamdi, S.; Almessiere, M.A.; Baykal, A.; Khan, F.; Adil, S.F.; et al. Sol–Gel Synthesis of Dy-Substituted Ni0. 4Cu0. 2Zn0. 4 (Fe2-xDyx) O4 Nano Spinel Ferrites and Evaluation of Their Antibacterial, Antifungal, Antibiofilm and Anticancer Potentialities for Biomedical Application. Int. J. Nanomed. 2021, 16, 5633. [Google Scholar]

| S.No. | Pharmacokinetic/ADME Properties | Fenchone |
|---|---|---|
| 1 | GI absorption | High |
| 2 | BBB permeant | Yes |
| 3 | P-gp substrate | No |
| 4 | CYP1A2 inhibitor | No |
| 5 | CYP2C19 inhibitor | No |
| 6 | CYP2C9 inhibitor | No |
| 7 | CYP2D6 inhibitor | No |
| 8 | CYP3A4 inhibitor | No |
| 9 | Log Kp (skin permeation) | −4.73 cm/s |
| 10 | Lipinski violations | 0 |
| 11 | Bioavailability Score | 0.55 |
| 12 | Number of rotatable bonds | 0 |
| 13 | Num. H-bond acceptors | 1 |
| 14 | Num. H-bond donors | 0 |
| 15 | Molar Refractivity | 45.64 |
| 16 | Topological Polar Surface Area | 17.07 Å2 |
| ProtParam Parameters | Values | |
|---|---|---|
| 1, 3-β–D-Glucan Synthase | Anthranilate-CoA Ligase | |
| Amino acids | 240 | 517 |
| Molecular weight | 28,162.98 | 56,607.52 |
| Theoretical Pi | 9.74 | 5.81 |
| Amino acidcomposition (%) | Ala =5.0%, Arg = 5.0%, Asn = 3.3%, Asp = 2.5%, Cys = 1.7%, Gln = 2.1%, Glu = 2.1% Gly = 3.3%, His = 0.8%, Ile = 10.4%, Leu = 14.2%, Lys = 5.8% Met = 4.2%, Phe = 7.1%, Pro =2.9%, Ser = 6.7%, Thr = 5.8% Trp = 2.5%, Tyr = 6.7%, Val = 7.9% | Ala = 11.8%, Arg = 8.1%, Asn = 2.3%, Asp = 6.0%, Cys = 2.3% Gln = 4.1%, Glu = 5.2%, Gly = 7.5%, His = 2.7%, Ile = 2.7%, Leu = 14.1%, Lys = 1.2%, Met = 1.0%, Phe = 4.4%, Pro =7.0%, Ser = 6.2%, Thr = 4.1%, Trp =1.4%, Tyr = 2.3%, Val = 5.6% |
| Negatively charged residues | 11 | 58 |
| Positively charged residues | 26 | 48 |
| Atomic composition | Carbon 1339 Hydrogen 2079 Nitrogen 313 Oxygen 322 Sulfur 14 | Carbon 2525 Hydrogen 3949 Nitrogen 717 Oxygen 732 Sulfur 17 |
| Formula | C1339H2079N313O322S14 | C2525H3949N717O732S17 |
| Total number of atoms | 4067 | 7940 |
| Extinction coefficient | 57,090 Abs 0.1% (=1 g/L) 2.027, assuming all pairs of Cys residues form cysteine | 57,130 Abs 0.1% (=1 g/L) 1.009, assuming all pairs of Cys residues form cysteine |
| Calculated half-life | 5.5 h (in vitro—mammalian reticulocytes). 3 min (in vivo—yeast). 2 min (in vivo—E. coli). | 0 h (in vitro—mammalian reticulocytes). >20 h (in vivo—yeast). >10 h (in vivo—E. coli). |
| Instability index | 37.99 (This indicates that the peptide is stable). | 41.80 (This indicates that the peptide is unstable). |
| Aliphatic index | 123.83 | 93.69 |
| Grand average of hydropathicity (GRAVY) | 0.656 | −0.068 |
| Receptor | PatchDock Score | Atomic Content Energy (ACE) (kcal/mol) | No. of H-Bonds | Amino Acid Residues |
|---|---|---|---|---|
| β-ketoacyl acyl carrier protein synthase I | 2794 | −131.30 | 7 | HIS298, PHE390, PRO272, HIS333, PHE229, PHE392 |
| Anthranilate-CoA ligase | 3412 | −113.15 | 4 | PRO283, ALA259, LEU494 |
| 1, 3-β–D-glucan synthase | 3124 | −130.89 | 5 | TYR197, TYR228, LEU232, PRO193, ILE235 |
| Strains | MIC | MBC |
|---|---|---|
| E. coli | 8.3 ± 3.6 a | 25.0 ± 0.0 d |
| MDR-P. aeruginosa | 266.6 ± 115.4 b | 533.3 ± 230.9 e |
| C. albicans | 41.6 ± 14.4 c | 83.3 ± 28.7 f |
Publisher’s Note: MDPI stays neutral with regard to jurisdictional claims in published maps and institutional affiliations. |
© 2022 by the authors. Licensee MDPI, Basel, Switzerland. This article is an open access article distributed under the terms and conditions of the Creative Commons Attribution (CC BY) license (https://creativecommons.org/licenses/by/4.0/).
Share and Cite
Ahmad, W.; Ansari, M.A.; Yusuf, M.; Amir, M.; Wahab, S.; Alam, P.; Alomary, M.N.; Alhuwayri, A.A.; Khan, M.; Ali, A.; et al. Antibacterial, Anticandidal, and Antibiofilm Potential of Fenchone: In Vitro, Molecular Docking and In Silico/ADMET Study. Plants 2022, 11, 2395. https://doi.org/10.3390/plants11182395
Ahmad W, Ansari MA, Yusuf M, Amir M, Wahab S, Alam P, Alomary MN, Alhuwayri AA, Khan M, Ali A, et al. Antibacterial, Anticandidal, and Antibiofilm Potential of Fenchone: In Vitro, Molecular Docking and In Silico/ADMET Study. Plants. 2022; 11(18):2395. https://doi.org/10.3390/plants11182395
Chicago/Turabian StyleAhmad, Wasim, Mohammad Azam Ansari, Mohammad Yusuf, Mohd Amir, Shadma Wahab, Prawez Alam, Mohammad N. Alomary, Abdulrahman A. Alhuwayri, Maria Khan, Abuzer Ali, and et al. 2022. "Antibacterial, Anticandidal, and Antibiofilm Potential of Fenchone: In Vitro, Molecular Docking and In Silico/ADMET Study" Plants 11, no. 18: 2395. https://doi.org/10.3390/plants11182395
APA StyleAhmad, W., Ansari, M. A., Yusuf, M., Amir, M., Wahab, S., Alam, P., Alomary, M. N., Alhuwayri, A. A., Khan, M., Ali, A., Warsi, M. H., Ashraf, K., & Ali, M. (2022). Antibacterial, Anticandidal, and Antibiofilm Potential of Fenchone: In Vitro, Molecular Docking and In Silico/ADMET Study. Plants, 11(18), 2395. https://doi.org/10.3390/plants11182395

